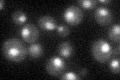
YBR237W

View description
RNA helicase in the DEAD-box family, necessary for prespliceosome formation, bridges U1 and U2 snRNPs and enables stable U2 snRNP association with intron RNA
Localization:
Intensity:
Fold change:
Significance:
-
C’ GFP library in SD
nucleus26.67 -
N' NOP1pr-GFP in SD

N/A0 -
N' TEF2pr-mCherry in SD

N/A0 -
N' NATIVEpr-GFP in SD

N/A0 -
N' TEF2pr-VC and Cyto-VN in SD

N/A0 -
C’ GFP library in SD+DTT

nucleus22.670.85No -
C’ GFP library in SD+H2O2

nucleus25.970.97No -
C’ GFP library in Starvation Media

nucleus21.850.81No -
C’ GFP library on the background of Pup2-DaMP

nucleus -
C’ GFP library on the background of CCT mutant

nucleus29.74481.11504No
